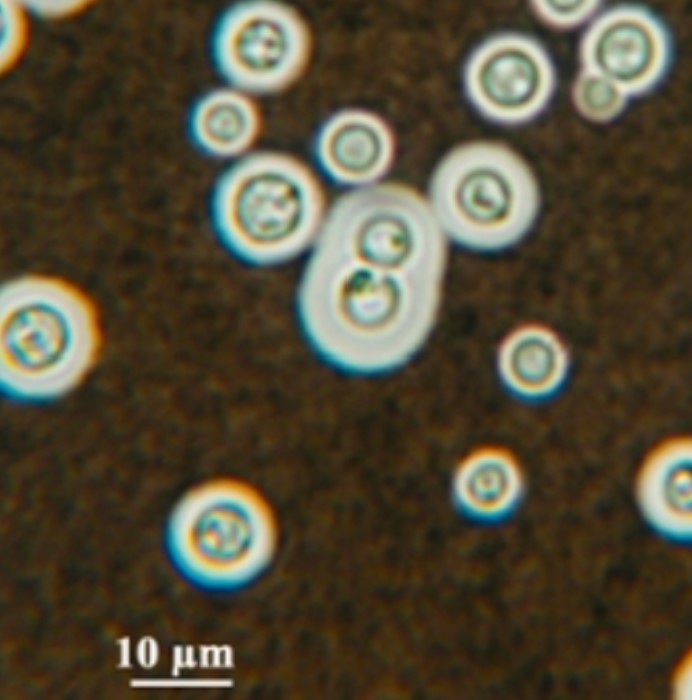

Inda Ink
GMS, PAS on histopath - narrow-based budding w/ large capsule
crypto
acellular, foamy, eosinophilic, intra-alveolar exudates on H&E
GMS/PAS stains on path = cysts (diff from alveolar proteinosis)
PJP
RF a/w chronic mucocutaneous candidiasis (disfiguring hyperkeratotic lesions, can have stricturing of esophagus)
Autoimmune regular (AIRE) gene mutation
STAT1 mutation
IL-7 receptor mutation
Dectin-1 deficiency
TLR-3 defect
chronic mucocutaneous candidasis
hypoPTH
adrenal insufficiency
autoimmune polyendocrinopathy-candidasis-ectodermal dystrophy/dyplasia (APECED)
Concerning/unique SEs of:
- itra
- vori
- itra - heart failure, cardiomyopathy
- vori - CNS and visual disturbances
Interpretation of histo Abs
H and M bands via immunodiffusion
M band: becomes + sooner. Seen with ANY exposure. persists for yrs
H band: only seen >20%. VERY spec for dissimen, chronic cavitary, severe acute pulm disease. Clears w/in 6mos
- H+M = active histo
- M alone = early/chronic disease
- >1:32 = highly sensitive for active infection
FP results with histo Ag
- blasto (commonly used to dx blasto)
- cocci
- talaromycosis
- paracocci
FP results with CrAg
(esp w/ latex agglutination methods)
- Trichosporon asahii
- Rothia
- Capnocytophaga
What are testing for with galactomannan?
What results in FP?
IAI
- FP: fusarium, penicillium, histo
- can have FP w/ zosyn or augmentin (though not in formulations after 2010)
- also w/ IVIG
Fungi that will/may test + with beta-D-glucan
- candida and invasive aspergillosis
- may see with histo and PJP as well
**(will always test negative with crypto and zygomycetes)
Generally considered a positive beta-D-glucan test
>80 pg/mL
Ampho-R Fungi
- C lusitaniae
- some isolates of C auris
- some fusarium spp (why empir AMB+VCZ)
- aspergillus terreus
- some scedosporium
- all lemontospora prolificans
- sporothrix
- pseudallescharia boydii
fever + skin lesions (starting as cellulitis, sometimes around toenails)
pt in engraftment period post-HSCT
dx and tx
Fusarium
empiric AMB + vori (diff spp have varying susc)
S China
SE Asia
a/w AIDS and IC hosts
cultures w/ red diffusible pigment
Clin: dissemination, skin, CNS, bone

talaromyces
- small oval non-budding yeast at 37C
- smooth conidiophores w/ 4-5 terminal metulae at 25-30C (above pic)
S America (male, farmer predominance)

Paracocci
large round thick-walled yeast w/ budding = ship’s wheel appearance at 37C (body temp)
SW US
N Mexico
Central/South America

Cocci
- round, thick-walled spherules containing endospores at 37C
- (septated branched hyphae w/ thick-walled arthroconidia at 25-30C)
MS and OH River valleys
St Lawrence Seaway
Africa, Asia, S America

Blastomyces
broad-based buddying yeast (37C = body temp)
(septated branched hyphae at 25-30C)
The B’s: broad based budding, breath (PNA), bone, brain, body (skin)
MS, OH River valleys
Histo
small oval budding yeast at 37C = body temp (2-5um)
septated hyphae w/ round/pear shaped microconidia at 25-30C
BSI
(rarely causes disease except when a/w probiotic use)

Saccharomyces
unicellular, globose, ellipsoid-elongated blastoconidia
multipolar budding
*cases of misID. If not on MALDI, consider C auris

- orange, red, “coral red” growth
- unicellular blastoconidia, globose-elongated shape
- no hyphae/pseudohyphae
Rhodotorula
Geotrichum
causes BSI, PNA in neutropenic pts
arthroconidia are unicellular/in chains/rectangle/barrel shaped

Trichosporon
- septated hyphae/pseudohyphae
- barrel-shaped arthroconidia (a sexual spore that is formed by breaking up of a hypha at point of septation
- pleomorphic budding yeast
- round budding yeast + capsule
- NO hyphae/pseudohyphae
- India ink, GMS/PAS
Crypto

Candida
- round-oval yeast w/ pseudohyphea
- clusters of blastoconidia at septa
















